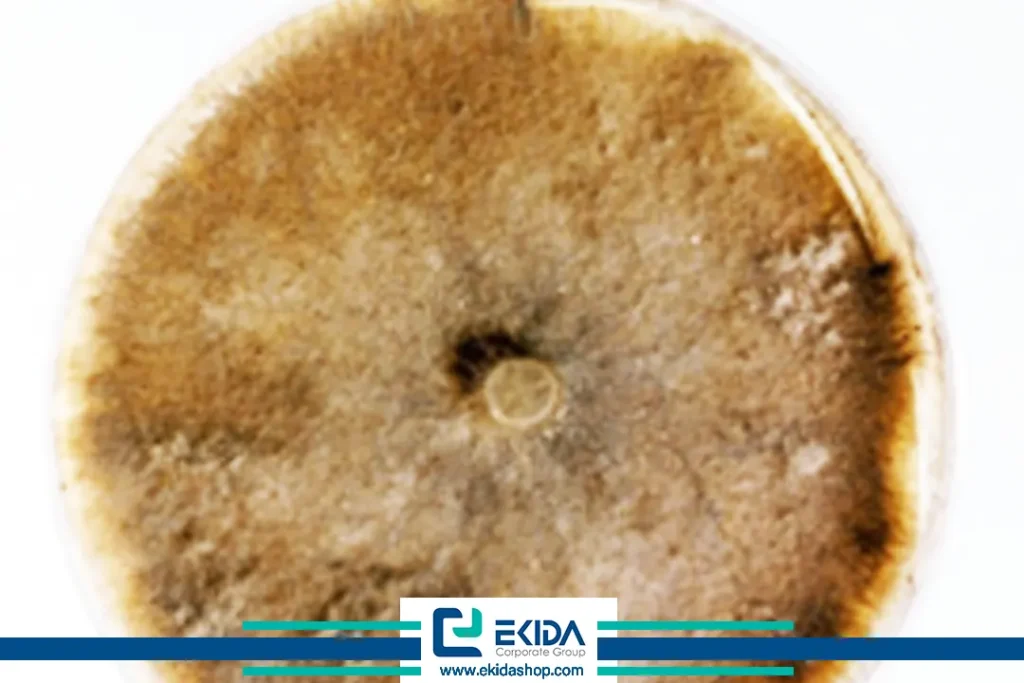

پاخوره (Take-all) یک بیماری قارچی خاکزاد در غلات است که بیشترین شدت خسارت آن در مزارع گندم مشاهده میشود. خسارت این بیماری در مناطق با بارندگی زیاد شدیدتر است. این بیماری میتواند سبب تضعیف شدید ریشه، کاهش رشد گیاه و در نهایت افت چشمگیر عملکرد محصول شود.
قارچ عامل این بیماری Gaeumannomyces graminis باعث پوسیدگی و سیاه شدن ریشه، طوقه و بسته شدن آوندها شده که به دنبال آن انتقال مواد از ریشه به بخش هوایی با مشکل مواجه شده و در نتیجه کوتاهی بوته، زرد شدن و حتی از بین رفتن گیاه اتفاق میافتد. اگر بوته زنده بماند رشد ضعیفی داشته و عملکرد آن شدیدا کاهش مییابد. در گیاهانی که دچار بیماری پاخوره شدهاند، اگر به خوشه هم بروند، دانهها چروک و تیره رنگ بوده و ساقه نیز براحتی خم شده یا ورس میکند و توانایی نگهداشتن سنبلهها را نخواهد داشت.
گستره میزبانی این پاتوژن تنها محدود به گندم نیست، بلکه محصولاتی مانند جو، یولاف، چاودار، تریتیکاله و برخی علفهای هرز گندمیان نیز در معرض خطر آلودگی قرار دارند. مدیریت این بیماری عمدتاً بر روشهای زراعی متکی است که موجب کاهش انتقال بیماری از یک فصل زراعی به فصل بعد میشوند.

عامل بیماری:
بیماری پاخوره یا تیکآل (Take all)، توسط دو واریته از قارچ Gaeumannomyces graminis به نامهای: Gaeumannomyces graminis var. tritici (Ggt) و Gaeumannomyces graminis var. avenae (Gga) ایجاد میشود. این قارچها به رده Ascomycota، زیر رده Sordariomycetes، راسته Magnaporthales و خانواده Magnaporthaceae تعلق داشته و قادر است برای مدت طولانی در بقایای گیاهی و خاک زنده بماند. این قارچ میتواند سالها بدون وجود گیاه زنده در بقایای آلوده غلات و میزبانهای دیگر زنده بماند و با شروع رشد ریشههای جدید میزبان به آنها حمله کند.
ساختارهای ویژه قارچ، مانند میسلیومهای تیرهرنگ (تصاویر ۲و۱) و سودوتسیوم (Pseudothecium) که به عنوان اندام تولیدکننده ساختارهای زایشی، در ناحیه طوقه و ریشه گیاه مشاهده میشوند، نقش مهمی در شناسایی بیماری ایفا میکنند. (تصویر ۳).



قارچ G. graminis برای فعالیت و رشد خود به دمای نسبتاً معتدل (بین ۱۰ تا ۲۰ درجه سانتیگراد) نیاز دارد و در این شرایط بیشترین آسیب را به محصول وارد میکند. قارچ بهویژه در خاکهای قلیایی، فشرده یا دارای زهکش ضعیف، فعالتر و قدرت آلودهکنندگی آن افزایش مییابد.
این پاتوژن خاکزی بهصورت مستقیم به بافتهای زنده ریشه و طوقه نفوذ کرده و باعث ایجاد پوسیدگی و از بین رفتن سیستم ریشهای میشود که در نهایت منجر به اختلال در جذب آب و عناصر غذایی و بروز علائم شدید بیماری در اندامهای هوایی خواهد شد. در آلودگیهای شدید، محصول بسیار کم بازده شده و در برخی موارد، برداشت محصول در نواحی آلوده صرفه اقتصادی ندارد. از این رو نام بیماری تیکآل (به معنی همه را از بین بردن) انتخاب شده است.

علائم و نشانههای بیماری:
علائم بیماری بهصورت تدریجی و در مراحل مختلف رشد گیاه میزبان ظاهر میشود. شناسایی بهموقع این نشانهها نقش کلیدی در پیشگیری از گسترش بیماری دارد. گیاهان آلوده ممکن است در پاییز یا اوایل بهار در مرحلهی گیاهچه و پنجهزنی (اوایل رشد)، اغلب کم رشد، کم رنگتر و متمایل به زرد هستند و معمولاً رشد قدی ضعیفی دارند. در موارد شدید، گیاهچهها قبل از آنکه به مرحله ساقه برسند از بین میروند.
علائم اولیه:
علائم اولیه اغلب مورد توجه قرار نمیگیرند یا ممکن است با شرایط دیگری مانند کمبود موادمغذی در خاک یا کمبود رطوبت اشتباه گرفته شوند. مشهودترین علائم بیماری تقریباً در زمان خوشهدهی و پس از آن ظاهر میشوند. مهمترین و مشخصترین علائم بیماری، سفید شدن خوشههای آلوده است (در زمانی که خوشههای بوتههای سالم هنوز سبز یا در حال رسیدن هستند). گیاهان آلوده زودتر از موعد طبیعی خشک (hay-off) میشوند و از بین میروند و معمولاً این مرگ و میر در لکههای دایرهای شکل در مزرعه رخ میدهد که بسته به شدت آلودگی، ممکن است از لکههای کوچک تا لکههای چند متری وسعت داشته باشند. (تصویر ۴).

علائم گیاهان آسیب دیده :
گیاهان آسیب دیده قبل از رسیدگی طبیعی، ظاهری سفید رنگ یا کاه مانند پیدا میکنند. همچنین میزان پنجهزنی کاهش مییابد بطوریکه اغلب فقط یک خوشه در هر گیاه تشکیل میشود (تصویر ۵). یا در موارد شدید بیماری، هیچ خوشهای شکل نمیگیرد. یا کاملاً فاقد دانه است یا دانههای آن شدیداً چروکیده و لاغر هستند. ظهور خوشههای سفید (white-heads) در اواخر فصل یکی دیگر از نشانههای احتمالی پاخوره است اگرچه سرمازدگی و کمبودهای ریزمغذی نیز میتوانند این علامت را ایجاد کنند (تصویر ۶).


علائم در ریشهها :
ریشههای اصلی، طوقهی گیاه و بافت ساقهی پایهای دچار پوسیدگی خشک میشوند. در صورت خارج کردن گیاه آلوده از خاک میتوان زخمهای مشخص قارچی را روی طوقه و ریشهها مشاهده کرد. این زخمها در شرایط مرطوب تا چند سانتیمتر بالای سطح خاک نیز گسترش مییابند. (تصویر ۷). سیاه شدن مرکز ریشه (stele) یکی از علائم اولیه آلودگی به بیماری پاخوره است. (تصویر ۸).


یک ویژگی تشخیصی کلیدی برای بیماری پاخوره تشکیل یک لایهی قارچی براق به رنگ قهوهای تیره تا سیاه در زیر غلاف برگ و در قسمت پایهی گیاه. (تصویر ۹). گیاهان بیمار معمولاً به دلیل حجم ریشه کم و پوسیدگی بهراحتی از خاک خارج شده و ریشه باقیمانده، شکننده و با انتهای بریده شده جدا میشود. (تصاویر ۱۰و ۱۱).



بطورکلی علائم بیماری پاخوره از زیر خاک شروع شده و با ضعف گیاه در جذب آب و مواد غذایی در نهایت منجر به سفید شدن خوشه و نابودی محصول میشود. رصد مزارع از اوایل رشد تا مرحله خوشهدهی برای شناسایی این علائم یکی از کلیدهای موفقیت در کنترل بیماری است. شناسایی دقیق بیماری پاخوره بهویژه در مراحل اولیه برای جلوگیری از گسترش آن ضروری است. تشخیص میتواند به صورت میدانی (ظاهری) یا در آزمایشگاه انجام شود.
روشهای تشخیص بیماری پاخوره گندم:
تشخیص میدانی:
تشخیص میدانی تشخیص در مزرعه معمولاً بر اساس علائم بالینی و فیزیولوژیک گیاه انجام میشود:
- سفید شدن خوشهها بهصورت لکهای
- زردی و پژمردگی در مراحل اولیه رشد
- کم رشدی و عقب افتادگی بوتهها در نقاطی از مزرعه
- خروج راحت بوته از خاک بهدلیل پوسیدگی ریشه
- مشاهده قارچ عامل بیماری و وجود لکههای سیاه و براق روی طوقه و ریشه (تصویر ۱۲ )
نکته: برای دیدن طوقه باید غلاف برگ پایینی را کنار زده و با دقت به قسمت پایین ساقه نگاه کرد.

تشخیص آزمایشگاهی:
در صورت نیاز به تایید نهایی یا مطالعه دقیقتر، نمونهها به آزمایشگاه منتقل میشوند:
- کشت روی محیطهای غذایی اختصاصی: قارچ عامل بیماری از طوقه یا ریشه جدا شده و در محیط کشت رشد داده میشود (تصویر ۱۳).
- مشاهده مستقیم زیر میکروسکوپ: رشتههای قارچی تیرهرنگ (هیفهای ملانینه) به وضوح در بخشهای آلوده دیده میشوند (تصویر ۱۴).

- تستهای مولکولی (در صورت دسترسی): مانند PCR جهت شناسایی دقیق گونه قارچ عامل بیماری.
ترکیب بررسی میدانی با آزمایشگاهی، شانس تشخیص سریع و صحیح این عامل بیماری را بالا میبرد. تشخیص به موقع، کلید جلوگیری از شیوع و اجرای راهکارهای کنترل مؤثر است.
چرخه بیماری و بقای پاتوژن:
این قارچ تابستان را بهصورت ساپروفیتی از طریق میسلیوم و ساختارهای مقاومی مانند سودوپریتسیوم در بقایای ریشهی گیاهان میزبان فصل قبل و همچنین روی علفهای هرز و غلات خودروی میزبان قارچ سپری میکند. بهمحض ایجاد شرایط محیطی مساعد (کاهش دما و شروع بارندگی در پاییز) و در دسترس بودن میزبان مناسب این قارچ فعال میشود و طی این دوره، به ریشههای گیاهان تازه جوانهزده حمله میکند.
عفونت اولیه گیاهان زمانی آغاز میشود که ریشه گیاهان جوان با بقایای آلوده قارچی در تماس قرار گیرند. در این مرحله، هیفهای قارچ روی سطح ریشه شروع به رشد کرده و نقاط مختلف ریشه را آلوده میسازند. این هیفها با تولید شاخههای ظریف، به اپیدرم ریشه نفوذ کرده و درون بافت آن گسترش مییابند. فرایند نفوذ هیفها، نقش مهمی در گسترش بیماریهای قارچی گیاهان دارد و یکی از مراحل کلیدی در توسعه بیماریهای خاکزاد به شمار میآید.
فعالیت قارچ در دمای ۱۰ تا ۲۰ درجه سانتیگراد به حداکثر خود میرسد بهویژه زمانی که خاک مرطوب دارای تهویه ضعیف و با pH قلیایی باشد. این شرایط معمولاً در اوایل بهار یا اواخر زمستان فراهم میشود، زمانی که گیاه به سرعت در حال رشد است و تقاضای بیشتری برای آب و مواد غذایی دارد. در این زمان، سیستم ریشهای آلوده قادر به تأمین نیازهای گیاه نیست و علائم زودرسی، سفید شدن خوشه و ضعف عمومی ظاهر میشوند.
دامنه گسترده میزبانی قارچ عامل بیماری پاخوره:
قارچ Gaeumannomyces graminis برخلاف تصور عمومی، تنها محدود به گندم و جو نیست. این پاتوژن به طیف وسیعی از گرامینهها حمله میکند و همین دامنه میزبانی گسترده یکی از دلایل پایداری و انتشار بالای بیماری در مزارع است.
میزبانهای اصلی:
- گندم (.Triticum spp): اصلیترین میزبان و درعینحال حساسترین گیاه در برابر این بیماری است. بسیاری از ارقام رایج گندم در ایران در برابر این قارچ آسیبپذیر هستند.
- جو (.Hordeum spp): نسبت به گندم مقاومت بیشتری دارد اما در شرایط خاص دچار آلودگی میشود و میتواند ناقل پنهان قارچ باشد.
- چاودار (Secale cereale): متحملترین میزبان در میان غلات رایج است و معمولاً با کمترین میزان خسارت مواجه میشود.
- تریتیکاله (Triticosecale x): بهعنوان هیبریدی از گندم و چاودار، حساسیت میانهای نسبت به بیماری دارد و در صورت کاشت در تناوبهای کوتاه با گندم میتواند چرخه بیماری را حفظ کند.
- علفهای هرز گرامینه: گونههایی مانند .Avena spp (یولاف وحشی)، .Bromus spp (علف پشمکی)، .Lolium spp (چچم) و سایر گندمیان خودروی بهعنوان میزبانهای مخفی عمل کرده و باعث حفظ قارچ عامل بیماری در خاک و بقایا میشود.
تنها گونه زراعی مقاوم به پاخوره، جو دوسر Oats با نام علمی Avena sativa است. هرچند گزارشهایی از سویههای G. graminis که در کشتهای متوالی جو دوسر باعث کاهش عملکرد شدهاند، وجود دارد.
این دامنه وسیع میزبانها نشان میدهد که مدیریت موفق بیماری، تنها با توجه به گندم کافی نیست بلکه باید کنترل علفهای هرز و طراحی تناوبهای زراعی هدفمند نیز در نظر گرفته شود.

عوامل موثر در شیوع و گسترش بیماری پاخوره:
گسترش بیماری پاخوره تحت تأثیر مجموعهای از عوامل محیطی، زراعی و مدیریتی است که شناخت آنها به مدیریت مؤثر بیماری کمک میکند.
۱.pH خاک:
افزایش pH خاک به سمت قلیایی باعث افزایش فعالیت قارچ و شدت بیماری میشود خاکهایی با pH بالاتر از ۷ بیشتر مستعد شیوع بیماری هستند. در خاکهای با pH پایین (اسیدی) معمولاً شدت بیماری کمتر است.
۲.تغذیه گیاه:
- کودهای ازته نیتراته (مثل نیترات آمونیوم) باعث افزایش شدت بیماری میشوند.
- مصرف کودهای ازته آمونیومی (مثل سولفات آمونیوم) که محیط اطراف ریشه را اسیدیتر میکند، میتواند بیماری را کاهش دهد.
- کمبود فسفر و ازت در خاک، باعث ضعیف شدن ریشه و افزایش حساسیت به بیماری میشود.
۳.نوع و روش آبیاری:
- آبیاری بیش از حد یا مداوم باعث افزایش رطوبت خاک و شرایط مطلوب برای رشد قارچ میشود.
- آبیاری غرقابی در شرایط خاص ممکن است شدت بیماری را افزایش دهد.
- روشهای نوین مانند آبیاری قطرهای میتواند به کنترل بهتر رطوبت و کاهش بیماری کمک کند.
۴.تراکم بوته و تاریخ کشت:
- کشت با تراکم زیاد، باعث کاهش تهویه خاک و افزایش رطوبت محیط اطراف ریشه میشود.
- تاریخ کشتهای زودهنگام یا خیلی دیر میتواند بر شدت بیماری تأثیرگذار باشد.
۵.بقایای گیاهی و علفهای هرز:
- بقایای آلوده گندم یا سایر گیاهان میزبان در خاک، منبع اولیه بیماری هستند.
- علفهای هرز میزبان میتوانند بهعنوان مخزن قارچ عمل کرده و بیماری را حفظ کنند.
راهکارهای مدیریتی برای پیشگیری و کاهش خسارت بیماری پاخوره گندم:
از آنجایی که ارقام مقاوم وجود ندارند و ضدعفونی بذر و استفاده از قارچکشها به صورت برگپاشی بیاثرند بنابراین، کنترل این بیماری عمدتاً بر روشهای مدیریتی زراعی متکی است که موجب کاهش انتقال بیماری از یک فصل زراعی به فصل بعد میشوند. برای کاهش خسارت بیماری و حفظ سلامت محصول، باید یک برنامه مدیریتی جامع اجرا شود که شامل روشهای مختلف زیر است:
۱.روشهای زراعی:
- تناوب زراعی: کشت گیاهان غیرمیزبان مثل حبوبات و ذرت به کاهش جمعیت قارچ در خاک کمک میکند.
- شخم عمیق: با دفن بقایای آلوده، جمعیت پاتوژن کاهش مییابد.
- کنترل علفهای هرز: زیرا برخی علفهای هرز میزبان قارچ هستند و میتوانند منبع آلودگی باشند.
- تنظیم تراکم بوتهها: تراکم زیاد باعث افزایش رطوبت و گسترش بیماری میشود پس بهتر است تراکم مناسب رعایت شود.
۲.استفاده از ارقام مقاوم و متحمل:
- انتخاب ارقام گندم مقاوم یا متحمل به بیماری مانند ارقام مرودشت، پارس و افلاک میتواند تاثیر زیادی در کاهش خسارت داشته باشد.
۳.تغذیه اصولی و مناسب:
- تامین مواد مغذی بهویژه فسفر و نیتروژن به شکل متعادل.
- مصرف کودهای آمونیومی (مثل سولفات آمونیوم) به جای کودهای نیتراته به دلیل اسیدی کردن خاک و کاهش شدت بیماری مفید است.
۴.تنظیم pH خاک:
- حفظ pH خاک در محدوده مناسب و جلوگیری از افزایش آن (pH بالای خاک شدت بیماری را افزایش میدهد).
۵.کنترل بیولوژیکی:
- استفاده از قارچهای مفید مانند Trichoderma harzianum و T. viride که میتوانند رشد قارچ بیماریزا را مهار کرده و به کاهش بیماری کمک نمایند.
۶.روشهای نوین آبیاری:
- استفاده از روشهای آبیاری بهینه که از رطوبت بیش از حد خاک جلوگیری کرده و شرایط غیرمساعد برای قارچ ایجاد میکند.
اجرای ترکیبی و همزمان این راهکارها به کشاورزان کمک میکند تا خسارت بیماری پاخوره را به حداقل برسانند و تولید محصول با کیفیت و پایدار داشته باشند.

نقش ترکیب زیستی بایوویتال درمدیریت زیستی بیماری پاخوره:
بایوویتال یک راهکار زیستی قدرتمند برای کاهش بیماری پاخوره است. این ترکیب حاوی باکتریهای مفید باسیلوس بخصوص subtilis Bacillus است که با رقابت با قارچ بیماریزا، تولید ترکیبات ضدقارچی و تحریک رشد گیاه، نقش کلیدی در کاهش شدت آلودگی دارد. باکتریهای مفید موجود در ترکیب زیستی بایوویتال با ایجاد بایوفیلم محافظتی روی ریشهها و القای مقاومت گیاه، به افزایش سلامت گیاه و عملکرد بهتر محصول کمک میکند. استفاده از این ترکیب، همراه با تناوب صحیح زراعی، روشی پایدار و مؤثر برای مهار پاخوره و بهبود بهرهوری زراعی است.

جمعبندی و توصیههای نهایی:
بیماری پاخوره یکی از مهمترین تهدیدها برای گندم و سایر غلات است که میتواند خسارتهای سنگینی به عملکرد و کیفیت محصول وارد کند. این بیماری ناشی از قارچ Gaeumannomyces graminis است که به ریشه و طوقه گیاه حمله کرده و با ایجاد زخم و سیاهشدگی، توانایی جذب آب و مواد غذایی را کاهش میدهد.
برای مدیریت مؤثر این بیماری باید از یک رویکرد تلفیقی استفاده کرد که شامل موارد زیر است:
- انتخاب و کشت ارقام مقاوم یا متحمل به بیماری
- رعایت اصول صحیح به زراعی مانند تناوب زراعی، شخم عمیق و کنترل علفهای هرز
- تیمار بذر با قارچکشهای مؤثر جهت حفاظت اولیه گیاهچه
- تغذیه متعادل با توجه به نیاز گیاه و تنظیم pH خاک به گونهای که شرایط برای قارچ بیماریزا نامناسب شود.
- کنترل بیولوژیکی با استفاده از قارچهای مفید مانند Trichoderma که رشد پاتوژن را مهار میکنند.
- بهکارگیری روشهای نوین آبیاری و مدیریت بهینه مصرف آب
همچنین پایش مستمر مزارع و تشخیص زودهنگام علائم بیماری از اهمیت ویژهای برخوردار است تا بتوان در مراحل اولیه اقدامهای کنترلی لازم را انجام داد و از انتشار بیماری جلوگیری کرد.
با اجرای این راهکارها میتوان ضمن حفظ سلامت مزارع گندم، عملکرد محصول را افزایش داده و خسارتهای اقتصادی ناشی از بیماری پاخوره را به حداقل رساند.


















